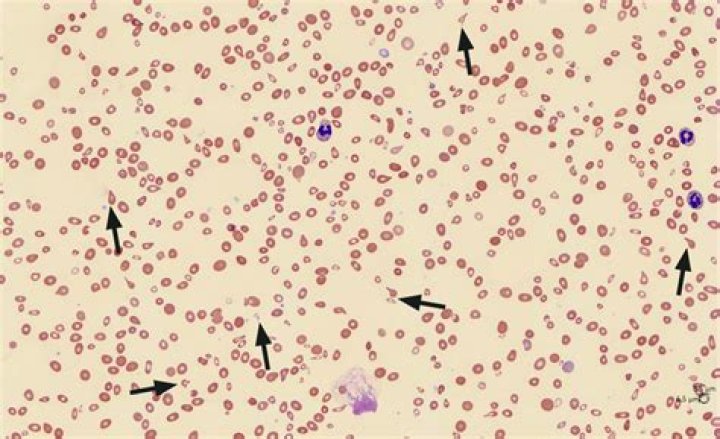

What is mild microcytosis
Microcytosis is a term used to describe red blood cells that are smaller than normal. When observed under the microscope on a blood smear, microcytosis is reported as “slight” to ++++ (“four plus”).
What does Anisocytosis 2 mean?
Anisocytosis is the medical term for having red blood cells (RBCs) that are unequal in size. Normally, a person’s RBCs should all be roughly the same size. Anisocytosis is usually caused by another medical condition called anemia. It may also be caused other blood diseases or by certain drugs used to treat cancer.
What are 3 types of anemia?
- Aplastic anemia.
- Iron deficiency anemia.
- Sickle cell anemia.
- Thalassemia.
- Vitamin deficiency anemia.
What is the most common cause of microcytic anemia?
The most common causes of microcytosis are iron deficiency anemia and thalassemia trait. Other diagnoses to consider include anemia of chronic disease, lead toxicity, and sideroblastic anemia.What causes Microcytosis in dogs?
The most common cause of microcytosis is iron deficiency. Iron-deficient cells can have normal diameter and appear normal on blood film despite decreased MCV and only in case of severe iron deficiency, microcytosis may be observed on the film.
What is the significance of Schistocytes?
Schistocytes or schizocytes are defined as circulating red blood cell fragments. Detection of schistocytes is an important clue for the diagnosis of thrombotic microangiopathy (TMA), which includes both thrombotic thrombocytopenic purpura (TTP) and hemolytic-uremic syndrome (HUS).
How serious is Macrocytosis?
However, macrocytic anemias can cause long-term complications if left untreated. These complications can include permanent damage to your nervous system. Extreme vitamin B-12 deficiencies may cause long-term neurologic complications. They include peripheral neuropathy and dementia.
What is Hypochromia and Microcytosis?
Hypochromic microcytic anemias Hypochromic means that the red blood cells have less hemoglobin than normal. Low levels of hemoglobin in your red blood cells leads to appear paler in color. In microcytic hypochromic anemia, your body has low levels of red blood cells that are both smaller and paler than normal.What causes Anisopoikilocytosis?
What causes anisopoikilocytosis? The most common causes of anisopoikilocytosis are blood disorders, like thalassemia and types of anemia, as well as other chronic disorders and nutritional deficiencies.
Why does Microcytosis decrease ESR?Factors Increasing ESRFactors Decreasing ESRMacrocytosisMicrocytosis (Hb C)Female genderSickle cells, spherocytesAge >50 yearsAnti-inflammatory medicationsObesityHypogammaglobulinemia
Article first time published onWhy do cells become Microcytic in iron deficiency anemia?
Iron deficiency hypochromic microcytic anemia is caused due to disruption of iron supply in diet due to decreased iron content in the diet, pathology of the small intestines like sprue and chronic diarrhea, gastrectomy, and deficiency of vitamin C in the diet.
How do you test for Microcytic anemia?
In microcytic hypochromic anemia, seek a source of bleeding. The appropriate laboratory tests are serum iron level and TIBC and either serum ferritin level or stain of bone marrow specimen for iron.
What level of anemia is severe?
Grade 1, considered mild anemia, is Hb from 10 g/dL to the lower limit of normal; grade 2 anemia, or moderate anemia, is Hb from 8 to less than 10 g/dL; grade 3, or severe anemia, is below 8 g/dL; grade 4, is life-threatening anemia; grade 5 is death (Table).
What foods to avoid if you are anemic?
- tea and coffee.
- milk and some dairy products.
- foods that contain tannins, such as grapes, corn, and sorghum.
- foods that contain phytates or phytic acid, such as brown rice and whole-grain wheat products.
- foods that contain oxalic acid, such as peanuts, parsley, and chocolate.
Which vitamins can lead to anemia?
Vitamins linked to vitamin deficiency anemia include folate, vitamin B-12 and vitamin C. Vitamin deficiency anemia can occur if you don’t eat enough foods containing folate, vitamin B-12 or vitamin C, or it can occur if your body has trouble absorbing or processing these vitamins.
What is MCV in dog blood?
Mean corpuscular volume: the MCV tells us the size of your dog’s red blood cells. It is useful because younger red blood cells are larger than mature red cells. If this number is high, it indicates red cells are turning over faster than expected. This can be due to bleeding or certain types of anemia.
When do you see Heinz bodies?
Heinz bodies may be present in patients with glucose-6-phosphate dehydrogenase (G6PD), or FAD f(adenine dinucleotide deficiency), i.e. methemoglobinemia. [6] it may also indicate unstable hemoglobin, e.g. HB Koln.
What is MCH in Haematology?
MCH stands for “mean corpuscular hemoglobin.” An MCH value refers to the average quantity of hemoglobin present in a single red blood cell. Hemoglobin is the protein in your red blood cells that transports oxygen to the tissues of your body.
What does macrocytosis 2+ mean?
Macrocytosis is a term used to describe red blood cells that are larger than normal. Also known as megalocytosis or macrocythemia, this condition typically causes no signs or symptoms and is usually detected incidentally on routine blood tests.
How serious is macrocytosis without anemia?
Macrocytosis without anemia is unlikely to result in specific signs or symptoms, and in many cases, may have minimal clinical significance. Patients should be screened for symptoms of anemia, including fatigue, generalized weakness, dyspnea, palpitations, lightheadedness, and syncopal or near-syncopal events.
What is macrocytosis a symptom of?
Macrocytosis is a condition in which your red blood cells are larger than they should be. While it isn’t a condition of its own, macrocytosis is a sign that you have an underlying health condition and may lead to a severe form of anemia called macrocytic normochromic anemia.
Are schistocytes the same as helmet cells?
Some of the irregular shapes appear as “helmet” cells. Such fragmented RBC’s are known as “schistocytes” and they are indicative of a microangiopathic hemolytic anemia (MAHA) or other cause for intravascular hemolysis.
What do schistocytes look like?
Schistocytes are fragmented red blood cells that can take on different shapes. They can be found as triangular, helmet shaped, or comma shaped with pointed edges. Schistocytes are most often found to be microcytic with no area of central pallor.
Are schistocytes present in thalassemia?
Schistocytes. Several fragmented RBCs per field, particularly with thrombocytopenia; suggest macroangiopathic hemolytic anemia. In the presence of hypochromic microcytic Heinz body–positive anemia, schistocytes suggest α-thalassemia variant (e.g., Hb H disease).
Is Anisopoikilocytosis serious?
There can be complications from the underlying condition that’s causing anisopoikilocytosis. Complications can include: pregnancy complications, including early delivery or birth defects. heart issues due to quick or irregular heartbeat.
Why would your Rdw be high?
High results If your RDW is too high, it could be an indication of a nutrient deficiency, such as a deficiency of iron, folate, or vitamin B-12. These results could also indicate macrocytic anemia, when your body doesn’t produce enough normal red blood cells, and the cells it does produce are larger than normal.
What are the symptoms of Poikilocytosis?
- fatigue.
- pale skin.
- weakness.
- shortness of breath.
What is dangerously high ferritin levels?
Many laboratories consider serum ferritin levels greater than 200 ng/mL in women and greater than 300 ng/mL in men to be abnormal.
What happens during Erythrocytosis?
Erythrocytosis is a condition in which your body makes too many red blood cells (RBCs), or erythrocytes. RBCs carry oxygen to your organs and tissues. Having too many of these cells can make your blood thicker than normal and lead to blood clots and other complications.
Can you be Anaemic with haemochromatosis?
Despite the high prevalence of comorbidities that are known risk factors for anemia in the general population, few patients with hereditary hemochromatosis develop anemia. Female patients with hereditary hemochromatosis are relatively protected against polycythemia, affecting only one-fourth of all patients with …
Is ESR 63 high?
ESR levels higher than 100 mm/hr could suggest a serious disease, such as infection, heart disease, or cancer [58, 5, 3, 6]. ESR levels higher than normal may predict cancer or cancer progression, like metastasis [59, 60, 61, 62, 63].



